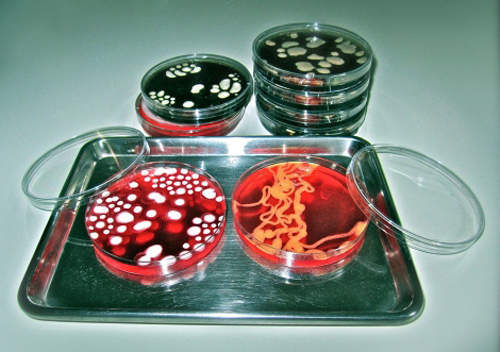
圖片7

《內臟馬卡龍》還只是18禁甜點的第一步!?

圖片來自:www.evilcakeshop.com
有沒有那種上完生物課,接著把內臟模型全部吃掉的班級?如果是用這一套內臟馬卡龍的話,的確頗有可能。沒事帶大家看日本可愛的甜點,怕大家太甜所以換個口味。這家開在倫敦的Evil Cake Shop,製作了各式各樣的「18禁甜點」,不是太過真實就是太過血腥甚至太過情色,所有看起來不該甜點的造型,全都出現在這裡。我也不確定可以放的尺度到哪裡,總之~先看看這「普級」的內臟馬卡龍吧!

圖片來自:www.evilcakeshop.com原汁原味的內容在這裡

圖片來自:www.evilcakeshop.com
原來馬卡龍也可以看起來如此不美味...

圖片來自:Lou Lou P`s Delights|Facebook
其實除了這些內臟外,連男女生的生殖器構造圖都可以出現在馬卡龍上!

圖片來自:www.evilcakeshop.com

圖片來自:www.evilcakeshop.com
絕對可能出現在課堂上的還有
像細菌培養皿一樣的果凍(噁)
圖片來自:www.evilcakeshop.com
如果覺得這些一點都不「惡魔」,其實逛了他們官網後會發現,真正適合「18禁」的應該還是以下這些蛋糕吧......

圖片來自:www.evilcakeshop.com

圖片來自:www.evilcakeshop.com
傳說中的陰牙人!?

圖片來自:www.evilcakeshop.com

圖片來自:www.evilcakeshop.com

圖片來自:www.refinery29.com/nsfw-cupcakes-didn-t-think-you-d-ever-see-that-before-did-you

圖片來自:www.refinery29.com/nsfw-cupcakes-didn-t-think-you-d-ever-see-that-before-did-you
馬麻,她口水好多喔~(大誤)
部分資料來自網路 ( EAT YOUR HEART OUT )

0 則回應
順序: 新│舊











































